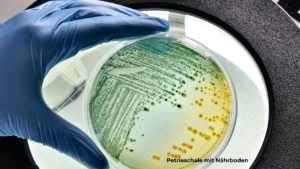

Mikrobiomanalyse oder klassische Stuhlflora? Was im Labor gemessen wird.
Hast du schon darüber nachgedacht, deinen Stuhl testen zu lassen? Klar, wer will nicht wissen, was da unten wirklich los ist. Vor allem, wenn der Bauch ständig Blähungen, Völlegefühl und Bauchschmerzen verursacht. Und schließlich hängt die Verdauung nicht nur mit dem Immunsystem zusammen, sondern mischt auch beim Stoffwechsel und sogar bei deiner Stimmung ordentlich mit.
Und dann stolperst du bei der Recherche plötzlich über zwei Begriffe: Stuhlfloraanalyse und Mikrobiomuntersuchung. Klingt erstmal ziemlich ähnlich, oder?
Aber: Nope! Die beiden Tests sind im Grunde wie Äpfel und Birnen. Beide beschäftigen sich zwar mit deinen Darmbakterien – aber auf ganz unterschiedliche Art. Und liefern am Ende total verschiedene Ergebnisse.
Was genau schauen die Tests sich an? Warum können sie dir wirklich helfen, deine Beschwerden besser zu verstehen? Und ganz wichtig: Welcher Test lohnt sich für dich überhaupt?
Inhaltsverzeichnis
1. Stuhluntersuchungen – auf der Suche nach den Übeltätern
Beim Erstgespräch frage ich immer: Wurde schon ein Stuhltest gemacht? Viele sagen: Ja, der Stuhltest beim Arzt war unauffällig – also alles okay. Oder?“ Stimmt nicht ganz!
1.1 Der klassische Stuhltest auf okkultes Blut
Du bekommst ein Probenset für zuhause und gibst dann die Probe dem Arzt zurück. Der Test wird auf nicht sichtbares Blut untersucht, das z.B. auf Polypen oder Tumore hinweisen kann.
1.2 Stuhluntersuchung in der Klinik oder Labor
Stell dir eine Petrischale vor, auf der Bakterien aus deiner Stuhlprobe gezüchtet werden. Die Methode ist besonders gut darin, typische Krankheitserreger wie Salmonellen, Shigellen oder Campylobacter sichtbar zu machen. Perfekt also, wenn du plötzlich Durchfall, Fieber oder Verdacht auf eine akute Infektion hast – denn so findet der Arzt schnell heraus, welcher Keim dahintersteckt und welche Therapie hilft. Was diese Kultur nicht kann: Sie zeigt nur die Bakterien, die wirklich wachsen können – und das sind nur etwa 1 Prozent aller Arten in deinem Darm. Die ganz große bunte Vielfalt bleibt im Dunkeln.
1.3 Stuhlfloraanalyse und moderne Mikrobiomuntersuchung
Nochmal eine andere Welt. Da geht’s nicht um einzelne Keim-Suche, sondern um das große Ganze. Wer lebt in deinem Darm zusammen und wie ist das Gleichgewicht?
Stuhlfloraanalyse
Hier wird dein Stuhl im Labor auf Nährmedien ausgebracht. Die Bakterien, die dort wachsen, werden bestimmt und gezählt. Es ist so etwas wie ein „klassischer Bakterientest“.
Typischerweise werden untersucht
- Gesamtkeimzahl: aerobe (benötigen Sauerstoff) Bakterien und anaerobe (benötigen kein Sauerstoff) Bakterien
- Hauptgruppen wie Lactobacillus, Bifidobacterium, E. Coli, Enterokokken und Clostridien
- Pathogene Keime wie Klebsiella, Proteus, Candida albicans oder Pseudomonas
- ph-Wert
Was du daraus erfährst: Wie gut deine Verdauung arbeitet, ob eine Fehlbesiedlung oder Pilzbelastung vorliegt.
Grenzen: Viele Darmbakterien sterben, sobald sie mit Luft in Kontakt kommen. Sie können also gar nicht „gezüchtet“ werden.
Bei den kulturellen Methoden wachsen die wenigsten der anaeroben Bakterien (die benötigen keinen Sauerstoff zum Leben – ca. 99 % der Darmbakterien). Hier wachsen ausschließlich die Aeroben Bakterien. (diese benötigen Sauerstoff um zu wachsen bzw. zum Leben). Das bedeutet: Keine Aussage zur Gesamtvielfalt, Balance oder Funktion des Mikrobioms. Gibt kein umfassendes Bild der Darmflora – ein wertvoller, aber begrenzter Ausschnitt.
Der DNA-Mikrobiomtest – die große Bestandsaufnahme
Die gängigste Methode ist die 16S-rRNA-Sequenzierung. Ein kurzer Abschnitt der bakteriellen DNA dient als „Barcode“, mit dem sich jede Bakterienart identifizieren lässt. Bei diesem Test wird das genetische Material aller Bakterien in deiner Stuhlprobe „ausgelesen“. So entsteht ein viel detaillierteres Bild: Welche Bakterien leben da? Wie viele verschiedene Arten sind es? Wie ist das Gleichgewicht – gibt es eine gesunde Mischung oder vielleicht eine Dysbalance? Dieser Test erkennt auch die stillen, schwer nachweisbaren und bislang unbekannten Mitbewohner. Das hilft, wenn du chronische Beschwerden, Verdauungsprobleme oder ein Gefühl, dass etwas nicht stimmt, hast.
Was dieser Test nicht kann: Er findet keine akuten „Schurken“ (z.B. Salmonellen), ist also nicht für Infektionen gedacht. Außerdem kann er nicht direkt sagen, ob die gefundenen Bakterien noch leben oder genau, was sie im Moment tun – er zeigt nur, dass sie da waren.
Gemessen wird:
- Zusammensetzung aller Bakterien im Stuhl (auch nicht kultivierbare Arten)
- Diversität (Vielfalt der Bakterien)
- Relative Häufigkeiten einzelner Gruppen
- Häufig auch funktionelle Daten: Produktion kurzkettiger Fettsäuren, Methanbildung, Schleimhautinteraktion
- Teilweise auch Pilze, Archaeen oder Viren
Was du daraus erfährst:
Wie vielfältig und stabil dein Mikrobiom ist, ob bestimmte Bakteriengruppen fehlen oder überwiegen und welche Stoffwechselaktivitäten dominieren.
Grenzen:
Diese Analysen erzeugen sehr viele Daten, deren Interpretation Erfahrung erfordert.
Nicht jede Abweichung ist pathologisch. Eine „abweichende Zusammensetzung“ bedeutet nicht automatisch Krankheit, sondern zeigt mögliche Ansatzpunkte.
Fazit
- Die klassische Kultur ist super bei akuten Infekten und für gezielte Therapien.
- Die Stuhlfloraanalyse gibt Hinweise ob eine Fehlbesiedlung oder Pilzbelastung vorliegt.
- Der DNA-Mikrobiomtest liefert ein umfangreiches Bild deiner gesamten Darmflora – ideal, um chronischen Problemen auf die Spur zu kommen.
Im Idealfall ergänzen sich beide Methoden – je nachdem, was bei dir gerade geklärt werden soll.
2. Was diese Untersuchungen wirklich bringen.
Beide Untersuchungen sind spannend – aber sie haben verschiedene Aufgaben.
2.1 🔬 Stuhlforaanalyse
Ideal bei akuten oder entzündlichen Beschwerden:
- Chronische oder wiederkehrende Durchfälle
- Nach einer Antibiotikatherapie
- Verdacht auf Pilze oder pathogene Keime
- Störungen der Fett- oder Eiweißverdauung
Damit findet man heraus, ob Keime überhandnehmen oder die Verdauung schwächelt.
👉 Sie nützt bei konkreten Behandlungsentscheidungen, z. B.: Antimikrobielle Therapie, Pilzbehandlung oder Gabe von Verdauungsenzymen.
2.2 🧬 Die Mikrobiomanalyse
ist nützlich, wenn du schon länger Beschwerden hast, aber niemand genau weiß, warum – etwa bei:
- Reizdarm
- SIBO
- ständiger Verstopfung oder wechselndem Stuhl
- Verdauungsproblemen
- Blähungen, Müdigkeit, Hautproblemen
👉 Hier entsteht der entscheidende Mehrwert: Die Ergebnisse zeigen Funktionsmuster, nicht nur Keimzahlen – und helfen, Therapieentscheidungen zu personalisieren.
3. Wann sind diese Analysen sinnvoll sind?
Ein Stuhltest ist eine einfache und schmerzfreie Möglichkeit, mehr über die Gesundheit deines Darms zu erfahren. Weil man nicht direkt in den Darm hineinschauen kann, gibt der Stuhl wichtige Hinweise darauf, wie die Verdauung funktioniert und wie deine Darmflora zusammengesetzt ist – also welche Bakterien dort leben.
Damit ein Stuhltest wirklich etwas bringt, sollte man vorher genau wissen, was man herausfinden möchte. Ein solcher Test macht vor allem Sinn,
👉 wenn du immer wieder Verdauungsbeschwerden hast,
👉 wenn du häufige Infekte oder chronische Beschwerden hast,
👉 wenn Therapien bisher wenig geholfen haben,
👉 wenn der Verdacht auf eine Dysbiose (ein Ungleichgewicht der Darmflora) oder eine Funktionsstörung besteht,
👉 oder um herauszufinden, ob dem Darm wichtige Stoffe fehlen (z.B. die Produktion von Butyrat – das ist eine Fettsäure, die deine Darmschleimhaut schützt),
Wenn alle üblichen Untersuchungen – wie Bluttests, Ultraschall oder Magenspiegelung – keine klare Ursache zeigen, kann ein gezielter Stuhltest helfen, den nächsten Schritt in der Diagnostik und Therapie zu gehen.
4. Ergebnisse richtig einordnen
Ein Laborergebnis ist ein Puzzleteil im Gesamtbild deiner Gesundheit. Die Werte müssen immer gemeinsam mit deinen Symptomen, deiner Krankengeschichte und anderen Untersuchungen betrachtet werden.
Worauf du noch achten solltest
- Du kannst einen solchen Test nicht verwenden, um eine Diagnose zu stellen.
- Wähle ein gutes Labor. Sie erklären ihre Ergebnis verständlich und zeigen, wie man sie nutzen kann.
- Achte zudem auf Zertifizierungen, wie beispielsweise ISO-Zertifizierungen, die für eine hohe Qualität und geprüfte Abläufe stehen.
- Ergebnisse mit Expert:innen besprechen. Nicht alles, was „auffällig“ aussieht, ist krankhaft.
Wie läuft eine Darmflora-Testung ab:
- Du bekommst deinen online bestellten Darmtest zugeschickt.
- Du entnimmst eine Stuhlprobe und schickst sie an das Labor. Für die Testung wird eine kleine Stuhlprobe entnommen und in dem im Test-Kit enthaltenen Röhrchen gelöst. Alles wird gut verschlossen, verpackt und ins Labor geschickt. In dem Proberöhrchen befindet sich eine Flüssigkeit, die die Stuhlprobe während des Rückversandes haltbar macht und deine Probe stabilisiert.
- Du füllst einen Fragebogen aus. Bei den meisten Tests ist das Ausfüllen eines online-Fragebogens empfohlen. Dieser beinhaltet Fragen, die für Auswertung relevant sind oder einen Einfluss auf das Mikrobiom haben können
- Du erhältst die Ergebnisse.
Die eigentliche Arbeit beginnt nach dem Test. Die Ergebnisse zeigen, wo du ansetzen kannst, um dein Mikrobiom wieder ins Gleichgewicht zu bringen.
Möchtest du mehr darüber erfahren, wie du deinen Darm im Alltag unterstützen kannst, dann informiere ich dich gerne in meinen weiteren Beiträgen – oder melde dich bei mir, wenn du dir eine individuelle Begleitung wünschst.
Du willst noch mehr Tipps rund um deine Darmgesundheit? Dann trag dich doch in meinen Newsletter ein.
Disclaimer: Die Inhalte dieses Blogartikels dienen ausschließlich der allgemeinen Information und ersetzen keinesfalls eine professionelle medizinische Beratung, Diagnose oder Behandlung durch einen Arzt oder Heilpraktiker. Bei gesundheitlichen Beschwerden oder anderen medizinischen Problemen solltest du immer einen qualifizierten Facharzt aufsuchen. Die vorgestellten naturheilkundlichen und wissenschaftlichen Empfehlungen sind sorgfältig recherchiert, ersetzen aber nicht die individuelle Beratung und Therapie durch einen Experten. Die Umsetzung der Tipps erfolgt auf eigenen Verantwortung.
Quellen: https://www.gutmicrobiotaforhealth.com/world-microbiome-day-2024-the-knowns-and-unknowns-of-the-potential-of-gut-microbiome-for-personalized-nutrition-advice/

Über mich: Mein Ansatz – medizinisch fundiert und ganzheitlich gedacht. Als Heilpraktikerin mit jahrelanger Praxiserfahrung, schaue ich nicht nur auf Symptome, sondern dorthin, wo Zusammenhänge sichtbar werden – zwischen Darm und dem gesamten Körper. Viele quälen sich jahrelang mit SIBO, Reizdarm und Verdauungsstörungen herum, ohne eine Erklärung zu bekommen. Ich schaue dorthin, wo andere oft aufhören. Ich glaube daran, dass niemand seine Beschwerden „einfach hinnehmen“ muss.




Liebe Silvia, dank sehr für diesen tollen, aufklärenden Artikel.
Sehr wertvoll, was du tust.
herzliche Grüsse Petra Büeler – petramachts
Liebe Petra, danke für deinen wertschätzenden Kommentar. Ich habe mich sehr gefreut. Ich verlinke hier deine Website, die mich sehr beeindruckt hat.https://www.petramachts.ch/
Herzliche Grüße Silvia